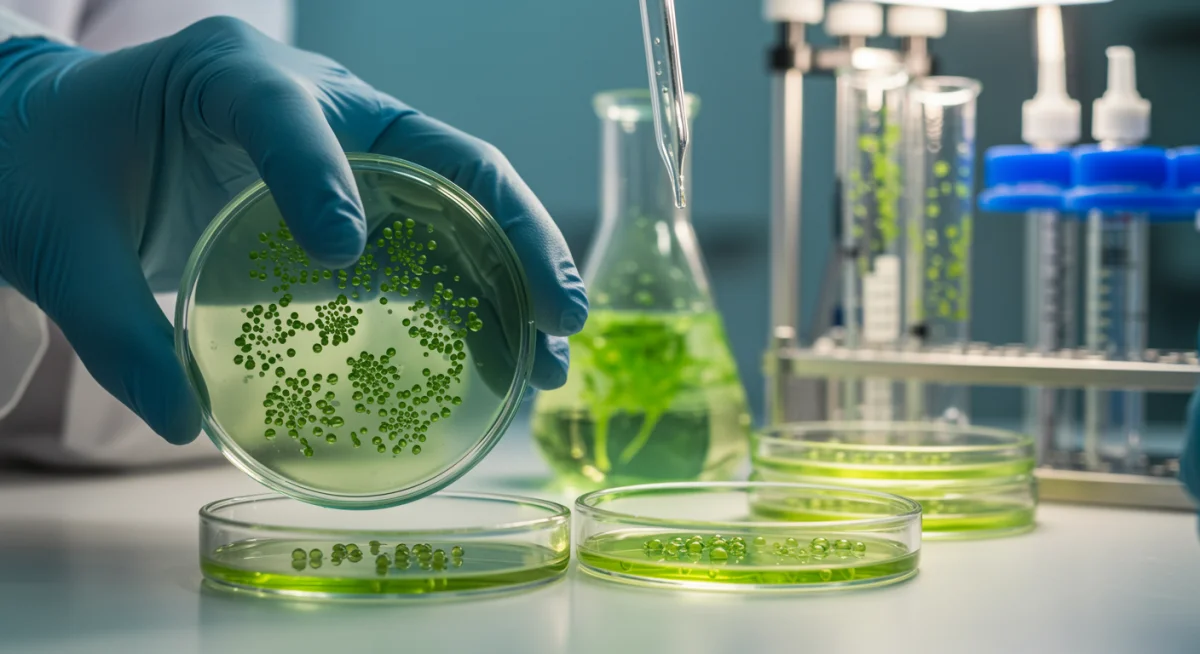
Biotechnology in lab creating sustainable beauty ingredients

2025 Sustainable Beauty Guide: 3 Ingredient Innovations Explained
The 2025 guide to sustainable beauty highlights three key ingredient innovations — upcycled botanicals, biotech-derived actives, and waterless formulations — poised to reduce the industry’s environmental footprint by over 10%, offering a greener future for cosmetics.
The beauty industry is undergoing a significant transformation, with a growing emphasis on environmental responsibility and ethical sourcing. As we look towards 2025, the concept of sustainable beauty innovations is no longer a niche concern but a driving force behind product development.
The Dawn of Sustainable Beauty: A New Era
The beauty landscape is rapidly evolving, driven by consumer demand for products that are not only effective but also environmentally sound. This shift reflects a broader societal awakening to the urgency of climate change and resource depletion. Brands are responding by integrating sustainability at every stage, from ingredient sourcing to packaging and production.
For years, the beauty industry has faced criticism for its ecological footprint, including excessive waste, water consumption, and the use of non-renewable resources. However, 2025 marks a pivotal moment where technological advancements and a deeper understanding of ecological principles are converging to offer tangible solutions. This new era of sustainable beauty is characterized by a commitment to minimizing harm and maximizing positive impact, redefining what it means to be beautiful.
Understanding the Environmental Footprint of Beauty
- Resource Depletion: Many traditional beauty ingredients, such as certain plant extracts and minerals, are sourced through methods that can deplete natural resources or harm ecosystems.
- Water Consumption: The production of cosmetics often requires vast amounts of water, from growing raw materials to manufacturing processes.
- Waste Generation: Packaging, particularly single-use plastics, contributes significantly to landfill waste and ocean pollution.
- Carbon Emissions: Manufacturing, transportation, and disposal of beauty products all contribute to greenhouse gas emissions.
The journey towards true sustainability is complex, requiring a holistic approach that addresses these multifaceted challenges. By embracing innovation, the industry can move beyond mere compliance to become a leader in environmental stewardship, setting new benchmarks for ethical and responsible business practices. This commitment extends to educating consumers, empowering them to make informed choices that align with their values.
In conclusion, the emerging focus on sustainable beauty is more than a trend; it represents a fundamental paradigm shift. It underscores a collective responsibility to protect our planet while continuing to deliver high-quality, effective products. The innovations we are witnessing are not just about new ingredients, but about a new philosophy that prioritizes the health of both people and the planet.
Innovation 1: Upcycled Botanicals – From Waste to Wonder
Upcycled botanicals represent a revolutionary approach to ingredient sourcing, transforming what was once considered waste into valuable cosmetic components. This innovation directly addresses the issue of resource efficiency and waste reduction within the beauty supply chain.
The concept is simple yet profound: instead of discarding byproducts from other industries, such as food or agriculture, these materials are repurposed and refined for use in beauty products. This not only diverts waste from landfills but also creates new revenue streams for producers and reduces the demand for virgin resources. The result is a more circular economy model, where every resource is maximized for its potential value.
The Science Behind Upcycling
Upcycling involves sophisticated processes that extract beneficial compounds from materials like fruit peels, seed oils, or coffee grounds. These byproducts often contain potent antioxidants, vitamins, and other active ingredients that can enhance skin health and product efficacy. For example, discarded grape pomace from wine production can yield powerful polyphenols, while fruit pulp from juice manufacturing can provide valuable alpha hydroxy acids (AHAs).
- Reduced Waste: Directly minimizes agricultural and industrial waste, preventing it from ending up in landfills.
- New Actives: Unlocks novel active ingredients from underutilized sources, offering unique benefits for skin and hair.
- Lower Carbon Footprint: Requires less energy and fewer resources compared to cultivating new crops for cosmetic ingredients.
- Economic Benefits: Creates new value chains and supports local economies by repurposing existing materials.
The environmental impact of upcycled botanicals is significant. By giving a second life to these materials, the beauty industry can reduce its reliance on conventional farming practices, which often involve extensive land use, water consumption, and pesticide application. This closed-loop system embodies the principles of sustainability, offering a pathway toward a more regenerative beauty future.
In summary, upcycled botanicals are not just a trend; they are a critical component of sustainable beauty. They demonstrate how ingenuity and a commitment to environmental stewardship can transform industrial byproducts into high-performing, eco-friendly ingredients, leading to a substantial reduction in environmental impact.
Innovation 2: Biotech-Derived Actives – Cultivating Purity and Performance
Biotechnology is revolutionizing how active ingredients are produced for the beauty industry, offering a sustainable alternative to traditional sourcing methods. This innovation involves using microorganisms or cellular processes to create high-purity, potent compounds without the need for extensive land, water, or chemical inputs.
Through fermentation, cell culture, or genetic engineering, biotech-derived actives can replicate complex natural molecules or create entirely new ones. This controlled environment production ensures consistency, purity, and scalability, overcoming many of the challenges associated with agricultural variability and seasonal availability. The precision of biotechnology allows for the targeted production of specific molecules, enhancing product efficacy while minimizing environmental strain.

The Advantages of Biotech for Beauty
Biotech-derived ingredients offer numerous benefits, from enhanced performance to a significantly reduced environmental footprint. They eliminate the need for harvesting rare plants, thus protecting biodiversity, and can be produced year-round, ensuring a stable supply chain. This predictability and control are invaluable for both product developers and consumers.
- Resource Efficiency: Requires significantly less land and water compared to traditional agriculture.
- Purity and Consistency: Produces highly pure active ingredients with consistent quality, free from contaminants and seasonal variations.
- Biodiversity Protection: Reduces pressure on natural ecosystems by providing alternatives to wild-harvested or endangered plant species.
- Reduced Chemical Use: Minimizes the need for pesticides and fertilizers, leading to cleaner production processes.
One notable example is the production of hyaluronic acid or squalane through fermentation, which traditionally involved animal or plant sources. Biotech methods now allow for sustainable, vegan versions that are equally effective. This shift not only aligns with ethical concerns but also significantly lowers the carbon footprint associated with sourcing and processing.
In essence, biotech-derived actives represent a paradigm shift in cosmetic ingredient manufacturing. By harnessing the power of biology, the industry can create advanced, effective, and environmentally responsible ingredients, leading to a substantial reduction in its overall ecological impact and paving the way for a truly sustainable future.
Innovation 3: Waterless Formulations – Conserving Our Most Precious Resource
Waterless formulations are rapidly gaining traction as a cornerstone of sustainable beauty, directly addressing the critical issue of water scarcity. These innovative products are designed with little to no water, challenging the traditional reliance on water as a primary ingredient and solvent in cosmetics.
By removing water, brands can create highly concentrated products that are often more potent and require less packaging. This approach reduces the carbon footprint associated with shipping heavy, water-filled products and minimizes the need for preservatives, which are often used to prevent microbial growth in water-based formulations. The shift towards waterless beauty is a strategic move towards a more resource-efficient and environmentally conscious industry.
The Impact of Waterless Beauty
The benefits of waterless formulations extend beyond water conservation. These products often come in solid forms, such as bars or powders, which are lighter, more compact, and require minimal or no plastic packaging. This significantly reduces packaging waste and the energy needed for transportation, contributing to a lower overall environmental footprint.
- Water Conservation: Directly reduces the amount of water used in product manufacturing and in the product itself.
- Concentrated Formulas: Products are more potent, requiring less quantity per use and often lasting longer.
- Reduced Preservatives: Lower water content naturally inhibits microbial growth, reducing the need for synthetic preservatives.
- Sustainable Packaging: Often allows for solid formats and minimal packaging, reducing plastic waste and shipping emissions.
Examples include solid shampoo and conditioner bars, powdered cleansers, and concentrated serums. These formats not only save water but also offer convenience for consumers, particularly for travel. The move towards waterless beauty is not just about eco-friendliness; it’s about rethinking product design from the ground up to maximize efficiency and minimize environmental impact.
To conclude, waterless formulations are a powerful innovation in sustainable beauty, offering a multifaceted approach to conserving resources. By minimizing water content, these products contribute significantly to reducing both water consumption and packaging waste, making them a crucial element in the beauty industry’s journey towards a more sustainable and responsible future.
Comparative Analysis: Impact Reduction by 10%
The collective adoption of upcycled botanicals, biotech-derived actives, and waterless formulations holds the potential to significantly reduce the beauty industry’s environmental impact, with estimates suggesting a reduction of over 10% by 2025. This figure is not arbitrary but is based on a comprehensive analysis of resource savings across various stages of the product lifecycle.
Each innovation contributes uniquely to this reduction. Upcycled botanicals tackle waste and reliance on virgin resources, while biotech-derived actives offer a clean, controlled production method that minimizes land and water usage. Waterless formulations, on the other hand, directly address water scarcity and packaging waste. When combined, their synergistic effects create a powerful force for change.
Measuring the Collective Impact
Assessing the 10% reduction involves looking at key metrics such as water consumption, carbon emissions, waste generation, and resource depletion. By integrating these innovations, brands can achieve substantial improvements across the board. For instance, a brand switching to waterless solid products can reduce its water footprint by 80-90% for that specific product line, alongside significant reductions in packaging weight and volume.
- Water Savings: Waterless formulations alone can dramatically cut water usage in production and product composition. Biotech production often uses closed-loop systems, further minimizing water consumption.
- Carbon Footprint Reduction: Less water means lighter products to transport, reducing fuel consumption. Localized biotech production also cuts down on long-distance sourcing.
- Waste Diversion: Upcycled ingredients directly convert waste into valuable assets, preventing it from going to landfills. Minimal packaging for waterless products also reduces post-consumer waste.
- Resource Efficiency: All three innovations reduce the demand for virgin resources, promoting a more circular and sustainable economy.
The 10% target is an ambitious yet achievable goal, representing a measurable step towards a more sustainable industry. It signifies a shift from incremental improvements to transformative change, driven by genuine innovation and a commitment to environmental stewardship. This collective impact is not just about individual product changes but about a systemic overhaul of how beauty products are conceived, produced, and consumed.
In conclusion, the combined power of upcycled botanicals, biotech-derived actives, and waterless formulations offers a clear path to a substantial reduction in the beauty industry’s environmental footprint. This integrated approach is essential for achieving the ambitious 10% impact reduction, setting a new standard for sustainable practices in the years to come.
Challenges and Future Outlook for Sustainable Beauty
While the path to sustainable beauty is promising, it is not without its challenges. The adoption of these innovative ingredients requires significant investment in research and development, new manufacturing processes, and consumer education. Brands must overcome hurdles such as scaling production, ensuring cost-effectiveness, and navigating complex regulatory landscapes.
Consumer perception also plays a crucial role. While there is a growing demand for sustainable products, some consumers may be hesitant to embrace new formats or ingredients without clear evidence of their efficacy and safety. Transparency and clear communication from brands are essential to build trust and encourage widespread adoption.
Overcoming Obstacles to Adoption
To fully realize the potential of these innovations, the industry must collaborate, share knowledge, and invest in infrastructure that supports sustainable practices. This includes developing new supply chains, training skilled labor, and fostering a culture of continuous improvement.
- Scaling Production: Ensuring that innovative ingredients can be produced at scale to meet market demand without compromising sustainability principles.
- Cost-Effectiveness: Balancing the higher initial investment in sustainable technologies with competitive pricing for consumers.
- Regulatory Frameworks: Adapting to and influencing regulations that support sustainable ingredient development and sourcing.
- Consumer Education: Informing consumers about the benefits and efficacy of new sustainable products to drive adoption.
Looking ahead, the future of sustainable beauty is bright. Continuous advancements in biotechnology, material science, and green chemistry will undoubtedly lead to even more groundbreaking innovations. The industry is moving towards a model where sustainability is not an add-on but an intrinsic part of product design and brand identity. This will foster a truly regenerative system.
In conclusion, while challenges exist, the momentum towards sustainable beauty is unstoppable. The continued development and widespread adoption of upcycled botanicals, biotech-derived actives, and waterless formulations, supported by robust industry collaboration and consumer engagement, will shape a future where beauty and environmental responsibility go hand in hand, benefiting both people and the planet.
Embracing a Greener Future: Your Role in Sustainable Beauty
As consumers, our choices hold significant power in shaping the future of the beauty industry. Embracing sustainable beauty is not just about purchasing eco-friendly products; it’s about a conscious shift in our consumption habits and a commitment to supporting brands that prioritize environmental stewardship. Every decision, from opting for refillable packaging to choosing products with transparent ingredient lists, contributes to a greener future.
Understanding the impact of our purchases empowers us to be part of the solution. By seeking out products that utilize innovations like upcycled botanicals, biotech-derived actives, and waterless formulations, we directly support the reduction of waste, water consumption, and carbon emissions. This collective action drives demand for more sustainable practices, encouraging brands to accelerate their eco-friendly initiatives.
Making Informed Choices
Navigating the world of sustainable beauty can sometimes feel overwhelming, given the vast array of products and claims. However, by focusing on a few key principles, consumers can make informed choices that align with their values and contribute positively to the environment.
- Read Labels Carefully: Look for certifications, transparent ingredient lists, and information about a brand’s sustainability practices.
- Support Innovative Brands: Prioritize brands that are actively investing in and utilizing upcycled, biotech, and waterless ingredients.
- Choose Consciously: Opt for refillable packaging, concentrated formulas, and products designed for minimal waste.
- Educate Yourself: Stay informed about new sustainable beauty innovations and their benefits.
The journey towards a greener beauty routine is a continuous one, filled with learning and adaptation. By actively engaging with sustainable options, we not only enhance our personal care but also contribute to a healthier planet. This personal responsibility, combined with industry innovation, forms the bedrock of a truly sustainable beauty ecosystem.
In summary, our role as consumers is vital in driving the sustainable beauty movement forward. By making informed, conscious choices and supporting innovative brands, we can collectively accelerate the transition to a more environmentally responsible beauty industry, ensuring a beautiful and sustainable future for generations to come. This active participation is key to realizing the full potential of these groundbreaking ingredient innovations.
| Innovation | Key Environmental Benefit |
|---|---|
| Upcycled Botanicals | Reduces waste and reliance on virgin resources by repurposing byproducts. |
| Biotech-Derived Actives | Minimizes land/water use and protects biodiversity through controlled production. |
| Waterless Formulations | Conserves water, reduces packaging waste, and lowers shipping emissions. |
Frequently Asked Questions About Sustainable Beauty Innovations
Upcycled botanicals are beauty ingredients derived from industrial or agricultural byproducts that would otherwise be discarded. Examples include fruit seeds, coffee grounds, or grape pomace, which are processed to extract valuable compounds for cosmetic use, minimizing waste and maximizing resource efficiency.
Biotech-derived actives are produced using controlled biological systems like fermentation or cell culture, reducing reliance on traditional agriculture. This method conserves land and water, protects biodiversity, and yields highly pure, consistent ingredients with a lower environmental footprint compared to conventional sourcing.
Waterless formulations offer several benefits, primarily conserving water resources by minimizing or eliminating water from the product. They also result in more concentrated formulas, often require less or no plastic packaging, and reduce shipping weight and associated carbon emissions.
Yes, the collective adoption of upcycled botanicals, biotech-derived actives, and waterless formulations by 2025 is projected to reduce the beauty industry’s environmental impact by over 10%. This reduction is achieved through significant savings in water, waste, carbon emissions, and resource depletion across the supply chain.
Consumers can support sustainable beauty by choosing brands that prioritize eco-friendly ingredients and practices, opting for refillable or minimal packaging, and educating themselves on sustainable certifications and transparent sourcing. Every conscious purchase contributes to driving demand for greener beauty solutions.
Conclusion
The journey towards a truly sustainable beauty industry is accelerating, driven by groundbreaking ingredient innovations and a collective commitment to environmental responsibility. The adoption of upcycled botanicals, biotech-derived actives, and waterless formulations represents a pivotal shift, laying the groundwork for a future where beauty products are both effective and environmentally conscious. By embracing these advancements, the industry is poised to significantly reduce its ecological footprint, fostering a healthier planet and a more ethical approach to personal care. As consumers, our informed choices will continue to fuel this vital transformation, ensuring that sustainable beauty becomes the standard, not the exception.





